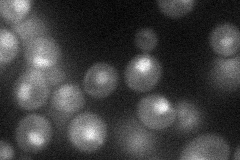
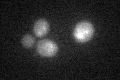

View description
Homeodomain-containing transcriptional repressor of PTR2, which encodes a major peptide transporter; imported peptides activate ubiquitin-dependent proteolysis, resulting in degradation of Cup9p and de-repression of PTR2 transcription
Localization:
Intensity:
Fold change:
Significance:
-
C’ GFP library in SD

below threshold15.57 -
N' NOP1pr-GFP in SD
nucleus30.8015 -
N' TEF2pr-mCherry in SD

below threshold6.05075 -
N' NATIVEpr-GFP in SD

missing0 -
N' TEF2pr-VC and Cyto-VN in SD

#N/A0 -
C’ GFP library in SD+DTT
cytosol14.920.95No -
C’ GFP library in SD+H2O2

cytosol17.141.09No -
C’ GFP library in Starvation Media

cytosol14.680.94No -
C’ GFP library on the background of Pup2-DaMP

below threshold -
C’ GFP library on the background of CCT mutant

below threshold17.1831.10237No
